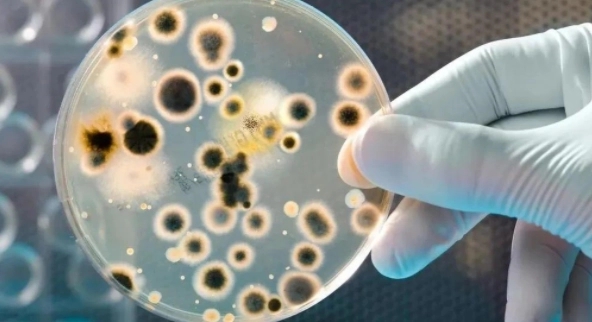
衣服为什么不可反过来晒,衣服怎么晒才正确的

#跟着瑶光看世界#
衣服在穿几天或几天后必须清洗,因为它们可能有很多灰尘和绒毛,或者隐藏着细菌和螨虫的数量。因此,为了安全起见,经常清洗是很有必要的。

但在清洗过程中,无论是手洗还是机洗,都会有大量水分进入衣物,必须烘干才能满足穿着条件。衣服会避免与人接触各种皮肤问题!

但是,究竟应该“正着晒”还是“反着晒”,却引起了争议!毕竟,衣服哪一面对着太阳,伤害会更大,会出现一系列的问题,比如褪色……

殊不知,不同的衣服在晒衣服的时候是有自己的细节的!根本不能一概而论!毕竟一旦衣服做错了,反而更容易显老!

我该怎么办?
那么,我就给大家做一个简单的介绍吧:

▼弄清楚怎么晒衣服?!
①尽量让*裤内**在阳光下暴晒,这样才能更好的达到杀菌消毒的效果!不过很多人都发错了,建议大家别反着晒了!

②羊毛、丝绸衣服最好不要直接在阳光下暴晒,否则长期阳光直射会使羊毛、丝绸衣服起皱、变形!

③针织衣服、化纤衣服、棉质衣服、麻类衣服一定要倒着晾干,这样才能避免衣服掉色的最大影响!间接延长了衣服的使用寿命!

▼深入了解洗涤误区,对症下药

[1]洗衣机用完就盖盖子
许多人通常在使用完洗衣机后立即盖上洗衣机盖,这样洗衣机里的水就没有机会蒸发了。殊不知,这样的事情很多,久而久之,洗衣机内积存的水,在阴暗潮湿的环境中,会不断滋生细菌和异味!
那么,再次使用洗衣机时,它会感染到衣服上,给人们带来各种麻烦,所以最好在使用完洗衣机后,将盖子打开过一会,用过后再盖上里面没有明显的水痕!

同时,我们要养成定期清洗洗衣机的习惯,不仅要解决洗衣机内桶上肉眼可见的污垢,还要消灭肉眼看不见的细菌和病毒,这样才能从源头上防止洗衣机成为污染源,对人造成或伤害轻伤或重伤!

在家里准备一些高端的便携式洗衣机片!
有空往洗衣机里放几颗洗衣机屎粒,不仅一步解决了洗衣机内桶隐藏的污垢和细菌味!

而且,它能长时间保持香味,在洗衣机内桶上形成一层保护层,防止污垢在洗衣机内部快速“沉淀”,加倍滋生细菌和异味,并使衣物旋转机器又成污染源了!

kinbata高端香氛款洗衣机槽清洗泡腾片深度清洁除菌 玫瑰香 一盒2
¥40.9
购买
[2]用得勤快却不洗
衣服鞋子基本天天换,但是很多人用的很热情却不洗,导致各种细菌病毒遍布衣服鞋子!到头来,直接或间接地威胁着全家人的健康!

建议准备多吸水的颜色床单,方便机洗衣服的大杂烩!
把深色或浅色的脏衣服全部扔进洗衣机,同时放上清洁用品,再扔1~2片吸色片,这样混合搅拌,省时省力。并尽量清洁衣服,也避免不同颜色的衣服串色!

日本KINBATA防染色衣服洗衣纸吸色片洗衣机吸色母片防串色洗衣片
¥29.9
购买
多准备泡沫洗衣粉!“手洗作弊的神器”!
不管是脏衣服还是脏鞋,只要简单地浸泡在混合洗衣粉后的水溶液中,就能轻松去除衣服和鞋子上的各种污垢!

而且,当窗帘、床垫等大件东西无法用洗衣机清洗时,只要准备一个大一点的容器,就可以靠洗衣粉轻松搞定!强力省力去污!

同时,泡泡洗衣粉还含有杀菌成分,能长时间抑菌,抑菌率高达97%。还能达到保养衣服面料的效果,防止因频繁洗涤导致的衣服发黄、发硬等问题!

另外,如果想加快去污速度,改变水温也能轻松达到目的!“使用70℃以下的水,水温越高,洗衣粉去污越快!”

Jepoo多功能泡沫清洁剂去污除油免洗清洗厨房用家用神器除垢王自
¥20.9
购买
最后总结
随着时代的发展,衣服的面料种类越来越多,每一种面料都有自己的特点,需要多加呵护,才能保证衣服能长久保持原状,才有可能!你对这个足够了解吗?如果没有,请关注了解更多!